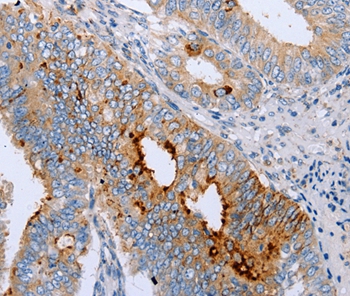

ENPP6 Antibody (aa359-408, HRP)
LS-C457130
ApplicationsWestern Blot
Product group Antibodies
TargetENPP6
Overview
- SupplierLifeSpan BioSciences
- Product NameENPP6 Antibody (aa359-408, HRP)
- Delivery Days Customer23
- Application Supplier NoteThe applications listed have been tested for the unconjugated form of this product. Other forms have not been tested.
- ApplicationsWestern Blot
- Applications SupplierWB The applications listed have been tested for the unconjugated form of this product. Other forms have not been tested.
- CertificationResearch Use Only
- ClonalityPolyclonal
- Concentration0.65 mg/ml
- ConjugateHRP
- Estimated Purity...
- Gene ID133121
- Target nameENPP6
- Target descriptionectonucleotide pyrophosphatase/phosphodiesterase 6
- Target synonymsB830047L21Rik; choline-specific glycerophosphodiester phosphodiesterase; ectonucleotide pyrophosphatase/phosphodiesterase family member 6; E-NPP 6; glycerophosphocholine cholinephosphodiesterase ENPP6; GPC-Cpde; NPP6; NPP-6
- HostRabbit
- IsotypeIgG
- Storage Instruction-20°C,2°C to 8°C
- UNSPSC12352203